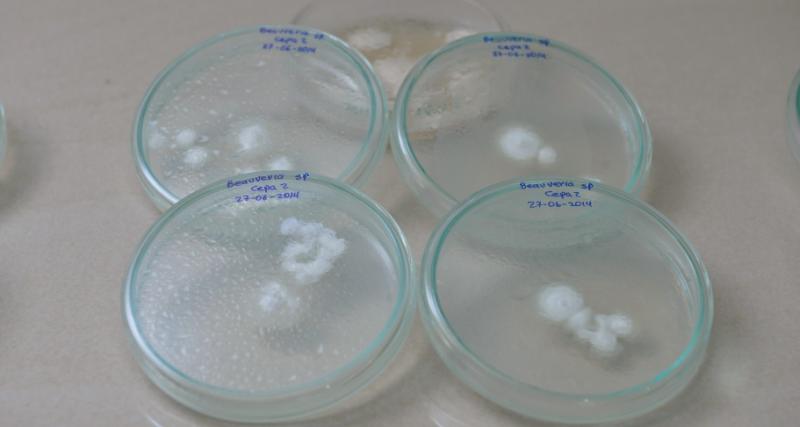
IDENTIFICACIÓN DE FITOPATÓGENOS

El servicio se encuentra orientado a la generación de un informe, en el que se reportan las especies de hongos, bacterias y virus en muestras proporcionadas por el usuario.
Este resultado sirve al usuario para identificar las plagas que pueden ocasionar daños a los cultivos, ocasionando pérdidas económicas.
Los beneficiarios de este servicio son el público en general, a quienes se les reporta mediante un informe técnico, la identificación de patógenos en muestras representativa de suelo, sustratos y plantas, proporcionada por el usuario, con la finalidad de determinar mecanismos para el control de plagas.
Dirigido a: Persona Jurídica - Privada, Persona Jurídica - Pública, Persona Natural - Ecuatoriana, Persona Natural - Extranjera.
Informe de resultados de laboratorio
Básico
- Comprobante de pago
- Muestra de suelos y plantas para análisis (100 gramos de muestra de raíz ó 1000 gramos de muestra de suelo)
Opcional
- Correo electrónico.
En línea
Presencial
Canales de atención: En línea (Sitio / Portal Web / Aplicación web), Presencial.
https://www.iniap.gob.ec/servicios/
Lugar: Estación Experimental Central de la Amazonía
Dirección:Km 3 vía Joya de los Sachas - San Carlos, cantón Joya de los Sachas, provincia de Orellana.
Horario: Lunes a Viernes, 8h00-16h30
Lugar: Estación Experimental Litoral Sur
Dirección: Km 26 vía Durán - Tambo, cantón Yaguachi, provincia de Guayas.
Horario: Lunes a Viernes, 8h00-16h30
Lugar: Estación Experimental Santa Catalina
Dirección:Panamericana Sur Km 1, parroquia Cutuglagua, cantón Mejía, provincia de Pichincha.
Horario: Lunes a Viernes, 8h00-16h30
Lugar: Estación Experimental Santo Domingo
Dirección: Km 38 vía Santo Domingo - Quinindé, cantón La Concordia, provincia de Santo Domingo de los Tsáchilas.
Horario: Lunes a Viernes, 8h00-16h30
Lugar: Estación Experimental Tropical Pichilingue
Dirección: Km.5 vía Quevedo - El Empalme, cantón Mocacha, provincia de Los Ríos.
Horario: Lunes a Viernes, 8h00-16h30
Contacto: Dirección de Producción, Comercialización y Servicios Especializadoss
Email: iniap@iniap.gob.ec
Teléfono: 022 504-240
Ley de Creación del Instituto en la que se detallan objetivos institucionales, organigrama, funciones y roles.
| # | Año-Mes | Volumen de Quejas | Volumen de Atenciones |
|---|---|---|---|
| 1 | 2026-01 | 0 | 0 |
| 2 | 2026-02 | 0 | 0 |
| 3 | 2026-03 | 0 | 0 |
| 4 | 2025-01 | 0 | 0 |
| 5 | 2025-02 | 0 | 0 |
| 6 | 2025-03 | 0 | 0 |
| 7 | 2025-04 | 0 | 0 |
| 8 | 2025-05 | 0 | 0 |
| 9 | 2025-06 | 0 | 0 |
| 10 | 2025-07 | 0 | 0 |
| 11 | 2025-08 | 0 | 0 |
| 12 | 2025-09 | 0 | 0 |
| 13 | 2025-10 | 0 | 0 |
| 14 | 2025-11 | 0 | 0 |
| 15 | 2025-12 | 0 | 0 |
| 16 | 2024-01 | 0 | 19 |
| 17 | 2024-02 | 0 | 13 |
| 18 | 2024-03 | 0 | 8 |
| 19 | 2024-04 | 0 | 13 |
| 20 | 2024-05 | 0 | 21 |
| 21 | 2024-06 | 0 | 0 |
| 22 | 2024-07 | 0 | 0 |
| 23 | 2024-08 | 0 | 0 |
| 24 | 2024-09 | 0 | 0 |
| 25 | 2024-10 | 0 | 0 |
| 26 | 2024-11 | 0 | 0 |
| 27 | 2024-12 | 0 | 0 |
| 28 | 2023-06 | 0 | 35 |
| 29 | 2023-12 | 0 | 38 |
| 30 | 2022-06 | 0 | 51 |
| 31 | 2022-12 | 0 | 46 |
| 32 | 2021-12 | 0 | 166 |
| 33 | 2020-12 | 0 | 94 |
| 34 | 2019-12 | 0 | 146 |
| 35 | 2018-12 | 0 | 139 |
| 36 | 2017-12 | 0 | 145 |
| 37 | 2016-12 | 0 | 140 |
Fecha de última actualización: 2022/09/14